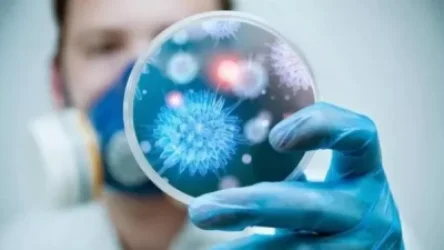
Հայաստանում հաստատվել է Covid-19-ի 650 նոր դեպք, մահացել է 15 մարդ

Խոշոր ավտովթար Արարատի մարզում. Nissan Tiida-ն կոտրել է երկաթե արգելապատնեշները, և հանդիպակաց գոտում ճակատ-ճակատի բախվել Toyota Camry-ին. կան վիրավորներ. Shamshyan. com

Այսօր խոշոր ավտովթար է տեղի ունեցել Արարատի մարզում: Ժամը 08:50-ի սահմաններում Երևան-Երասխ ավտոճանապարհի 25-րդ կմ հատվածում Nissan Tiida մակնիշի ավտոմեքենան դեպի Երասխ ընթանալիս, դեռևս անհայտ հանգամանքներում, դուրս է եկել ճանապարհի երթևեկելի գոտուց, բախվել բաժանարար գոտու երկաթե արգելապատնեշներին, կոտրել դրանք, դուրս եկել հանդիպակաց երթևեկելի գոտի և ճակատ-ճակատի բախվել դեպի Երևան ընթացող Toyota Camry մակնիշի ավտոմեքենային: Այս մասին հայտնում է Shamshyan.com-ը:
Ինչպես դեպքի վայրից հայտնում է Shamshyan.com-ը, վթարի հետևանքով 3 հոգի մարմնական վնասվածքներով տեղափոխվել են «Արտաշատ» բժշկական կենտրոն, որտեղից էլ 2-ին տեղափոխել են Երևանի «Էրեբունի» բժշկական կենտրոն: Ոստիկանությունը պարզում է վարորդների և վիրավորների ինքնությունը:
Մանրամասները՝ կայքում: